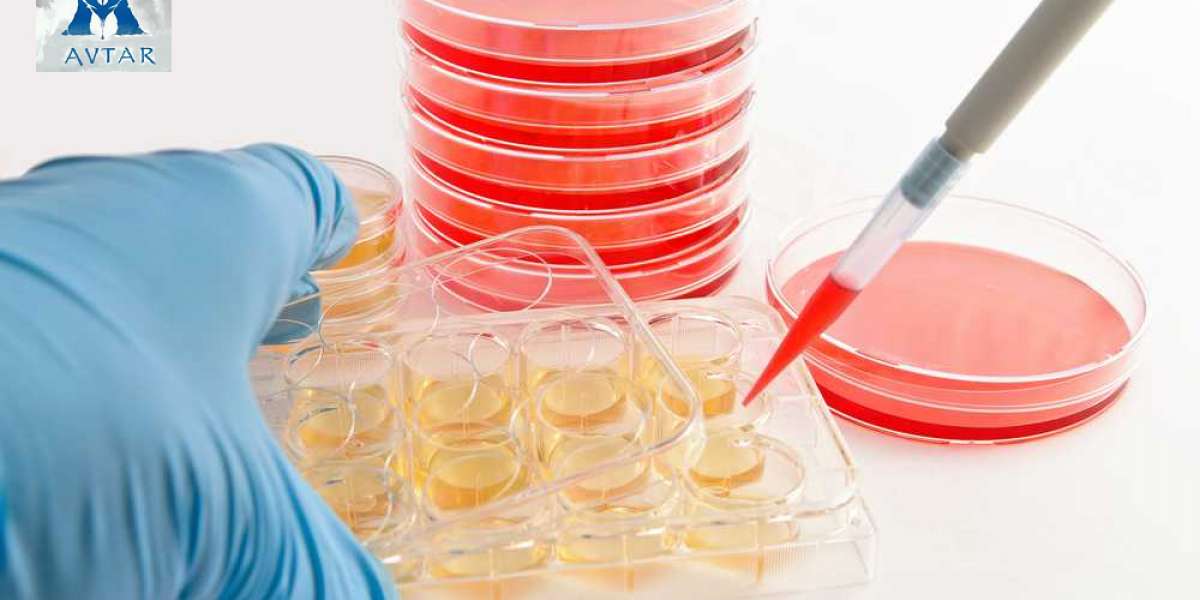
Automated Cell Culture Market Report Witness the Industry to have a Steady Rise

Automated Cell Culture Market Report Witness the Industry to have a Steady Rise | #automated Cell Culture Market
Automated Cell Culture Market Report Witness the Industry to have a Steady Rise | #automated Cell Culture Market
Digital Health Market Size Benefits from the Huge Surge in Internet Connectivity | #digital Health Market